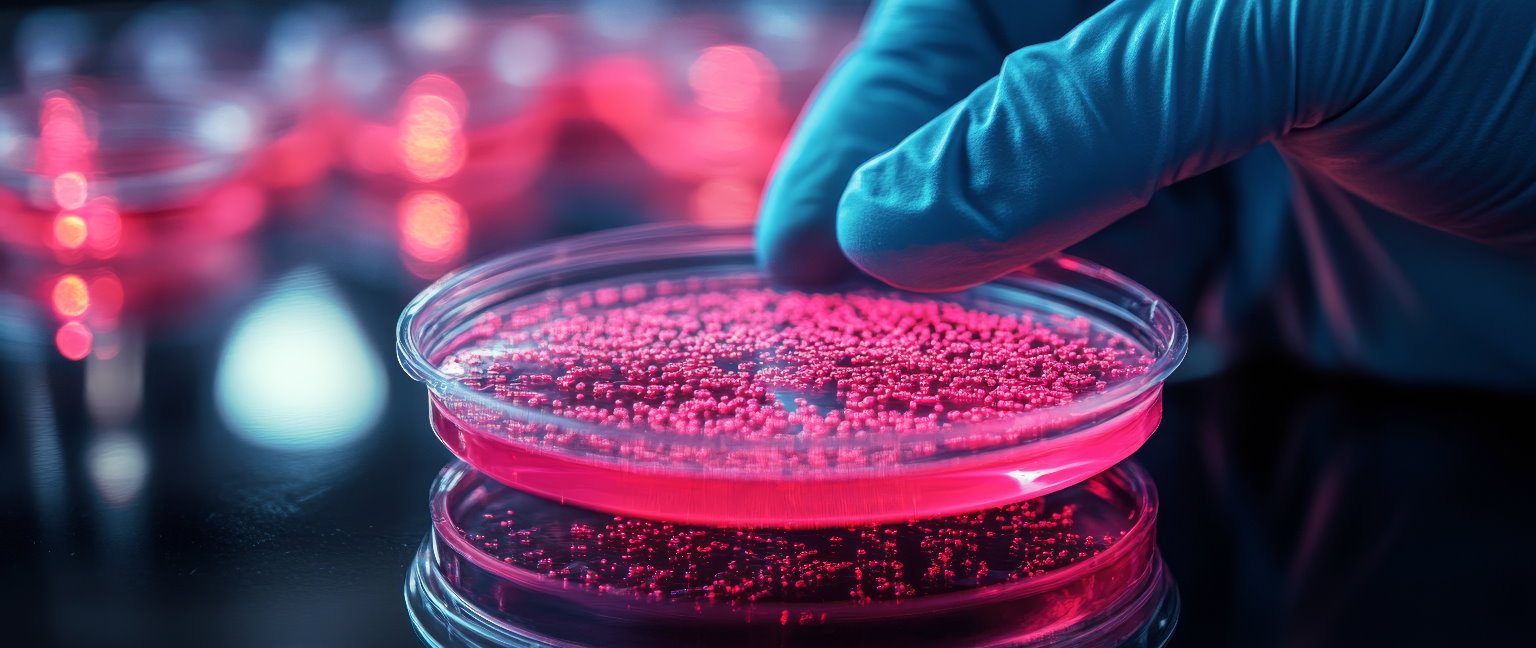

Certificate
Basic Microbiology Techniques
Course Outline
This course introduces learners to the fundamental laboratory techniques used in microbiology. Students will explore how microorganisms are handled, cultured, observed and analysed in controlled laboratory environments.
The course focuses on essential practical skills, including aseptic techniques, preparation of culture media, microbial isolation and basic identification methods.
Learners will combine theoretical knowledge with hands-on laboratory activities to develop competence in safely working with microorganisms and interpreting microbiological results.
Key Information
- MQF/EQF Level: Not pegged/recognised by MFHEA
- ECTS: N/A
- Qualification/Certification Type: Certificate of Completion
- Course Duration: 5 weeks × 6 hrs/week
- Total Hours: 30 hours
- Delivery Mode: In-person (hands-on lab-based)
- Language of Instruction: English & Maltese
- Target Audience: 16+ years
Students must complete at least 85% of total learning hours (tracked via attendance logs, lab participation and assessment submissions). A Certificate of Completion will be issued accordingly.
Course Description
Microbiology plays a critical role in healthcare, food safety, environmental monitoring and biotechnology. This unit provides a practical introduction to the core techniques used to study microorganisms in laboratory settings.
The course begins by introducing laboratory safety, sterile techniques and the proper handling of microbiological equipment. Learners will explore how contamination is prevented and controlled.
The unit then focuses on the preparation of culture media and the use of aseptic techniques to isolate and grow microorganisms. Students will learn streaking, spreading and inoculation methods to obtain pure cultures.
Learners will investigate microbial growth patterns and environmental factors affecting growth, such as temperature, pH and nutrient availability.
The course also introduces basic microscopy techniques for observing microorganisms, as well as simple staining methods to differentiate cell types.
The unit concludes with basic identification techniques and interpretation of results, including colony morphology and simple biochemical tests.
Throughout the course, learners will develop practical laboratory skills, accuracy in technique and an understanding of microbiological workflows.
Entry Requirements
- Basic understanding of general science
- No prior laboratory experience required
Target Audience
This course is designed for:
- Biology students (secondary or early tertiary level)
- Health and life sciences learners
- Laboratory assistants and technicians
- Food safety and quality control personnel
- Individuals interested in microbiology and laboratory work
- Science enthusiasts seeking hands-on experience
Course Delivery
The programme is structured into seven modules, delivered through:
- Instructor-led lectures
- Interactive discussions
- Case studies and comparative analysis
- Visual presentations and diagrams
- Group activities
- Short assessments and quizzes
Course Structure
- Module 1 – Introduction to Microbiology and Lab Safety
- Module 2 – Aseptic Techniques and Sterilisation Methods
- Module 3 – Preparation of Culture Media
- Module 4 – Microbial Culturing Techniques (Streaking, Spreading, Inoculation)
- Module 5 – Microbial Growth and Environmental Factors
- Module 6 – Microscopy and Staining Techniques
- Module 7 – Identification of Microorganisms (Colony Morphology & Basic Tests)
- Practical Assessment / Final Evaluation
Assessment & Certification
Assessment methods include:
- Practice quizzes
- Module-based assessments
- Short written assignments
- Final graded assessment
Upon successful completion, learners will receive a Certificate in Basic Microbiology Techniques.
Learning Outcomes
By the end of this course, learners will be able to:
- Apply laboratory safety procedures in microbiology settings.
- Demonstrate correct aseptic techniques to prevent contamination.
- Prepare and sterilise culture media.
- Perform microbial culturing techniques to obtain pure cultures.
- Analyse factors affecting microbial growth.
- Use microscopes to observe microorganisms.
- Perform basic staining techniques.
- Identify microorganisms using simple laboratory methods.
Course Intake Dates & Pricing
May 2026
Price: EUR 600
